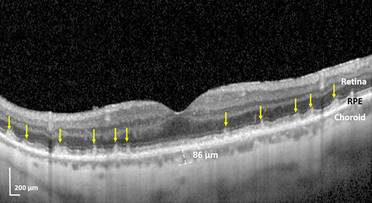
Study: Blinding Eye Disease Strongly Associated With Serious Forms of Cardiovascular Disease image

Study: Form of AMD Strongly Associated With Cardiovascular Disease
Patients with a specific form of age-related macular degeneration (AMD) are also highly likely to have either underlying heart damage from heart failure and heart attacks, or advanced heart valve disease, or carotid artery disease associated with certain types of strokes, according to a new study from New York Eye and Ear Infirmary of Mount Sinai.
This research, published November 17 in BMJ Open Ophthalmology, is the first to identify which types of high-risk cardiovascular and carotid artery disease are linked to the eye disorder. The findings could prompt increased screening to save vision, diagnose undetected heart disease, and prevent adverse cardiovascular events.
“For the first time, we have been able to connect these specific high-risk cardiovascular diseases to a specific form of AMD, the one with subretinal drusenoid deposits (SDDs),” lead author R. Theodore Smith, MD, PhD, Professor of Ophthalmology at the Icahn School of Medicine at Mount Sinai, said in Mount Sinai news release. “This study is the first strong link between the leading cause of blindness, AMD, and heart disease, the leading cause of death worldwide. Furthermore, we also have strong evidence for what actually happens: the blood supply to the eye is directly diminished by these diseases, either by heart damage that diminishes blood supply throughout the body, or from a blocked carotid artery that directly impedes blood flow to the eye. A poor blood supply can cause damage to any part of the body, and with these specific diseases, the destroyed retina and leftover SDDs are that damage. Retinal damage means vision loss, and can lead to blindness.”
One major form of early AMD consists of small yellow cholesterol deposits called drusen, which form under a part of the retina called the retinal pigment epithelium (RPE). They can deprive the retina of blood and oxygen, leading to vision loss. Drusen formation can be slowed by appropriate vitamin supplementation. The other major form of early AMD, subretinal drusenoid deposits (SDDs), are less well-known, and require high-tech retinal imaging to detect. These deposits contain a different form of cholesterol, and form above the RPE, and just beneath the light-sensitive retina cells, where the damage occurs and vision is lost. There is no known treatment for SDDs. Dr. Smith and a team of Mount Sinai researchers initially found that patients with cardiovascular disease or stroke were more likely to have SDDs. That first-of-its-kind research was published in the July issue of Retina. This new study expands on that previous work, looking at a larger patient population, and identifies the specific severe forms of heart disease and carotid artery disease that caused the SDDs of AMD.
Researchers analyzed the eyes of 200 AMD patients with retinal imaging to determine which patients had SDDs. Patients answered a questionnaire about their history of cardiovascular disease. Of the 200 patients, 97 had SDDs and 103 had drusen only. Forty-seven of the 200 had severe heart disease (19 had heart damage from heart failure or heart attack, 17 serious valve disease, and 11 stroke stemming from the carotid artery). Forty of the 47 (86 percent) had SDDs. By contrast, of the 153 AMD patients who did not have these severe diseases, 57 had SDDs (43 percent). The researchers concluded that AMD patients with these severe cardiovascular diseases and stroke were nine times more likely to have SDDs than those without them.
“This work demonstrates the fact that ophthalmologists may be the first physicians to detect systemic disease, especially in asymptomatic patients,” says co-investigator Richard B. Rosen, MD, Chief of the Retina Service for the Mount Sinai Health System. “Detecting SDDs in the retina should trigger a referral to the individual’s primary care provider, especially if no previous cardiologist has been involved. It could prevent a life-threatening cardiac event.”
The next step is for researchers to focus on patients in cardiology and neurology clinics to further examine varying degrees of cardiovascular and carotid disease and assess that possible relationship of disease severity to AMD with SDD.
This study was funded by a Regeneron Pharmaceuticals Investigator-Initiated Study, Research to Prevent Blindness Challenge Grant, the Macula Foundation, a Bayer-Global Ophthalmology Award, and the International Council of Ophthalmology-Alcon Fellowship.
Figure: Damaged retina of study participant with a previous heart attack.
The abnormal subretinal drusenoid deposits (SDDs) are the multiple, gray, conical lesions (yellow arrows) sitting on top of the bright white band known as the retinal pigment epithelium (RPE). They are pushing and penetrating the thin white retinal layer above them. All the other retinal layers further above are normal. The eye’s blood supply, seen below the RPE and known as the choroid, is abnormally thin because the weakened heart is not pumping enough blood to the eye.
